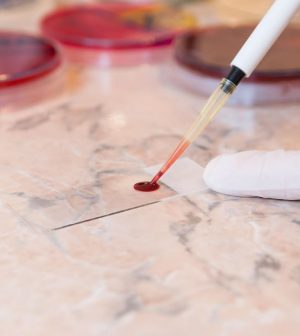

- How Blue Light Impacts Your Sleep Quality
- Comparing Whey and Plant-Based Protein: Which is Best?
- How Long Does Nicotine Remain in Your System?
- The Best Time of Day to Drink Bone Broth to Maximize Health Benefits
- 8 Ways to Increase Dopamine Naturally
- 7 Best Breads for Maintaining Stable Blood Sugar
- Gelatin vs. Collagen: Which is Best for Skin, Nails, and Joints?
- The Long-Term Effects of Daily Turmeric Supplements on Liver Health
- Could Your Grocery Store Meat Be Causing Recurring UTIs?
- Are You Making This Expensive Thermostat Error This Winter?
Blood Tests Can Detect Cancer Years Earlier
Blood tests can detect evidence of cancer three years earlier than the disease would otherwise be diagnosed, a new small-scale pilot study says.
The test — called a multicancer early detection (MCED) test — looks for genetic material that’s shed by tumors into the bloodstream.
The test revealed cancer DNA that was circulating in some patients’ blood up to three-and-a-half years prior to their diagnosis with cancer, according to results recently published in the journal Cancer Discovery.
“Detecting cancers years before their clinical diagnosis could help provide management with a more favorable outcome,” said senior researcher Nickolas Papadopoulos, a professor of oncology at the Ludwig Center at Johns Hopkins in Baltimore.
“Of course, we need to determine the appropriate clinical follow-up after a positive test for such cancers,” he added in a news release.
For the study, researchers assessed blood samples collected for a large-scale, federal-funded research project focused on heart disease.
The team used the MCED test to compare 26 study participants who were diagnosed with cancer within six months of providing the blood sample against 26 similar participants who didn’t develop cancer.
Eight of the 52 blood samples scored positively on the MCED test, and those eight people were diagnosed with cancer within four months of providing the sample, results showed.
Three had colon cancer, and one each had pancreatic, rectal, lung, breast or liver cancer. Five of the eight patients eventually died from their cancers.
Looking further back, researchers obtained blood samples for six of the eight patients that had been drawn three to three-and-a-half years prior to their cancer diagnosis.
The team found tumor-shed DNA in four of those earlier samples, indicating that those patients’ cancers could have been caught years earlier.
“This study shows the promise of MCED tests in detecting cancers very early, and sets the benchmark sensitivities required for their success,” senior researcher Dr. Bert Vogelstein said in a news release. He’s a professor of oncology and co-director of the Ludwig Center at Johns Hopkins.
Larger studies are needed to confirm these findings, but the results indicate that this sort of blood test could very well help catch cancers at an earlier, more survivable stage, researchers said.
“The focus of our study was not to demonstrate the performance of a new MCED test, but rather to demonstrate how early [bloodborne cancer DNA] can be detected by any MCED test,” researchers wrote in their paper.
Researchers also noted that detecting cancers three or more years prior to diagnosis will require blood tests that are 50 times more sensitive than those used to detect cancers six months prior to diagnosis.
“Establishing technologies for achieving this benchmark is a worthy future goal,” the team wrote.
More information
The American Cancer Society has more on multicancer early detection tests.
SOURCES: Johns Hopkins Medicine, news release, June 4, 2025; Cancer Discovery, May 22, 2025
Source: HealthDay
Copyright © 2026 HealthDay. All rights reserved.










